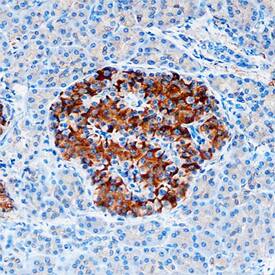
beta-Catenin antibody in Human Pancreas by Immunohistochemistry (IHC-P).

Human beta-Catenin Antibody
R&D Systems, part of Bio-Techne | Catalog # MAB13291


Conjugate
Catalog #
Key Product Details
Species Reactivity
Validated:
Human
Cited:
Human
Applications
Validated:
Immunohistochemistry, Western Blot, Immunocytochemistry
Cited:
Immunohistochemistry, Immunohistochemistry-Paraffin, Western Blot, Flow Cytometry, Immunocytochemistry, Immunoprecipitation
Label
Unconjugated
Antibody Source
Monoclonal Mouse IgG3 Clone # 196618
Product Specifications
Immunogen
E. coli-derived recombinant human beta-Catenin
aa 2-781
aa 2-781
Specificity
Detects human beta-Catenin in direct ELISAs.
Clonality
Monoclonal
Host
Mouse
Isotype
IgG3
Scientific Data Images for Human beta-Catenin Antibody
beta‑Catenin in SW480 Human Cell Line.
beta-Catenin was detected in immersion fixed SW480 human colorectal adenocarcinoma cell line using 10 µg/mL Mouse Anti-Human beta-Catenin Monoclonal Antibody (Catalog # MAB13291) for 3 hours at room temperature. Cells were stained with the NorthernLights™ 557-conjugated Anti-Mouse IgG Secondary Antibody (red; Catalog # NL007) and counter-stained with DAPI (blue). View our protocol for Fluorescent ICC Staining of Cells on Coverslips.beta‑Catenin in Human Pancreas.
beta-Catenin was detected in immersion fixed paraffin-embedded sections of human pancreas using Mouse Anti-Human beta-Catenin Monoclonal Antibody (Catalog # MAB13291) at 1.7 µg/mL overnight at 4 °C. Tissue was stained using the Anti-Mouse HRP-DAB Cell & Tissue Staining Kit (brown; Catalog # CTS002) and counterstained with hematoxylin (blue). Specific staining was localized to plasma membranes. View our protocol for Chromogenic IHC Staining of Paraffin-embedded Tissue Sections.Detection of Human beta-Catenin by Immunocytochemistry/Immunofluorescence
Overview of Multi-dimensional Microscopic Molecular Profiling (MMMP).The overall MMMP approach is depicted using an example tissue section from normal human duodenum (sample #1.9.7). (a) Slides were subjected to repeated cycles of staining and imaging with fluorescent primary antibodies and DAPI. At the end of each cycle, fluorescent signal was removed by a chemical bleaching process, and slides were again imaged, before proceeding to the next round of this iterative procedure. After the final antibody stain (#15 Sma), slides were analyzed with a series of histochemical stains. (b) A set of tiling images spanning each tissue section was initially generated by the microscope system. The tiling images were then computationally ‘stitched’ together to produce a single image per staining cycle for each sample. (c) Image registration was performed to align images from the same tissue section across cycles. Mean intensities of the DAPI signal from all immuno-fluorescence images are shown from before (Unregistered) and after (Registered) the image registration procedure was completed. (d) Following registration, signal intensities from the relevant channels for each image (columns) in the MMMP series were extracted for each pixel (rows) within the tissue section and compiled into a large data matrix of in situ molecular profiles. Image collected and cropped by CiteAb from the following publication (https://dx.plos.org/10.1371/journal.pone.0128975), licensed under a CC-BY license. Not internally tested by R&D Systems.Applications for Human beta-Catenin Antibody
Application
Recommended Usage
Immunocytochemistry
8-25 µg/mL
Sample: Immersion fixed human neuroectodermals differentiated from embryonic stem cells and immersion fixed SW480 human colorectal adenocarcinoma cell line
Sample: Immersion fixed human neuroectodermals differentiated from embryonic stem cells and immersion fixed SW480 human colorectal adenocarcinoma cell line
Immunohistochemistry
8-25 µg/mL
Sample: Immersion fixed paraffin-embedded sections of human pancreas
Sample: Immersion fixed paraffin-embedded sections of human pancreas
Western Blot
1 µg/mL
Sample: Recombinant Human beta-Catenin
Sample: Recombinant Human beta-Catenin
Reviewed Applications
Read 5 reviews rated 4.8 using MAB13291 in the following applications:
Formulation, Preparation, and Storage
Purification
Protein A or G purified from hybridoma culture supernatant
Reconstitution
Reconstitute at 0.5 mg/mL in sterile PBS. For liquid material, refer to CoA for concentration.
Formulation
Lyophilized from a 0.2 μm filtered solution in PBS with Trehalose. *Small pack size (SP) is supplied either lyophilized or as a 0.2 µm filtered solution in PBS.
Shipping
Lyophilized product is shipped at ambient temperature. Liquid small pack size (-SP) is shipped with polar packs. Upon receipt, store immediately at the temperature recommended below.
Stability & Storage
Use a manual defrost freezer and avoid repeated freeze-thaw cycles.
- 12 months from date of receipt, -20 to -70 °C as supplied.
- 1 month, 2 to 8 °C under sterile conditions after reconstitution.
- 6 months, -20 to -70 °C under sterile conditions after reconstitution.
Background: beta-Catenin
Alternate Names
bCatenin, CTNNB1
Gene Symbol
CTNNB1
Additional beta-Catenin Products
Product Documents for Human beta-Catenin Antibody
Product Specific Notices for Human beta-Catenin Antibody
For research use only
Loading...
Loading...
Loading...
Loading...
Loading...